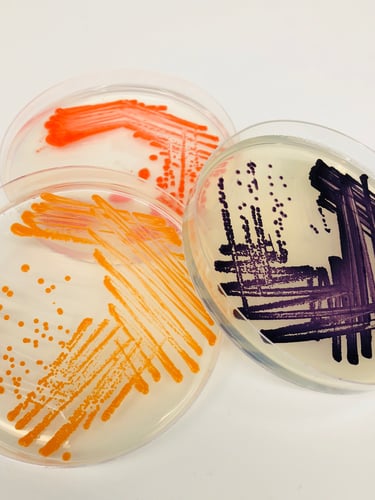

Az Indigo biotrinsic® termékeinek tudományos alapjai
biotrinsic® termékek hogyan fejlesztettük ki?

1. Felfedezés
Olyan növényekből vettek mintát, amelyek stresszes körülmények között is erősek maradtak, majd ezeket elemezték.2. Fejlesztés
A legnagyobb potenciállal rendelkező mikrobákat először laboratóriumban, majd üvegházi, végül szántóföldi kísérletekben tesztelték biotrinsic® termékként.3. Kereskedelmi forgalmazás
A legsikeresebb biotrinsic® termékek piacra kerültek, és úgy lettek kialakítva, hogy összhangban működjenek a növényekkel és a tápanyagokkal.Folyékony porok hogyan tapadnak a magra?

Az Indigo termékek fehér foltok formájában tapadnak a magok felületére, és áttetsző porrétegként jelennek meg. A mikrobáknak nem szükséges teljesen befedniük a mag felszínét. Összehasonlításképp: egyetlen kukoricaszem 10'000-szer nagyobb egy mikrobiális sejtnél.
A folyékony por, akárcsak a magfelület, pozitív és negatív ionokat tartalmaz. Ez az elektrosztatikus töltés biztosítja, hogy a por vetés közben rátapadjon a magra.
Mit jelent ez a növény és a földje számára?
A hagyományos kémiai termékek hatása idővel csökken, míg élő mikrobáink szaporodnak, és egész szezonban kifejtik jótékony hatásukat. Beépülnek a növény fiziológiájába, támogatva annak növekedését és ellenálló képességét.

Egyetlen magra körülbelül 1000 mikrobát juttatunk.

Egy hónapon belül ez a szám meghaladja a 250.000.000-et.

Ez hektáronként 13,6 trillió mikrobát jelent.
Merre tartunk
Az elmúlt évtizedekben a mezőgazdasági termelékenység folyamatosan növekedett az új termesztési technikák, szintetikus műtrágyák, nemesítési tulajdonságok és más ipari technológiák megjelenésének köszönhetően. Ez a növekedés azonban mára megtorpant, és a termelékenység egyfajta plató szakaszba ért. De mi lenne, ha ahelyett, hogy a terméshozam további növelését hajszolnánk, inkább arra összpontosítanánk, hogy a növényeket megerősítsük azokkal a környezeti stresszhatásokkal szemben, amelyek megakadályozzák a globális termés akár kétszeresére vagy háromszorosára növelését?
Az Indigo által megálmodott jövő éppen ez. Mikrobáról mikrobára dolgozunk azon, hogy áttörjük a jelenlegi termelékenységi határokat, és új szintre emeljük a modern mezőgazdaságot.